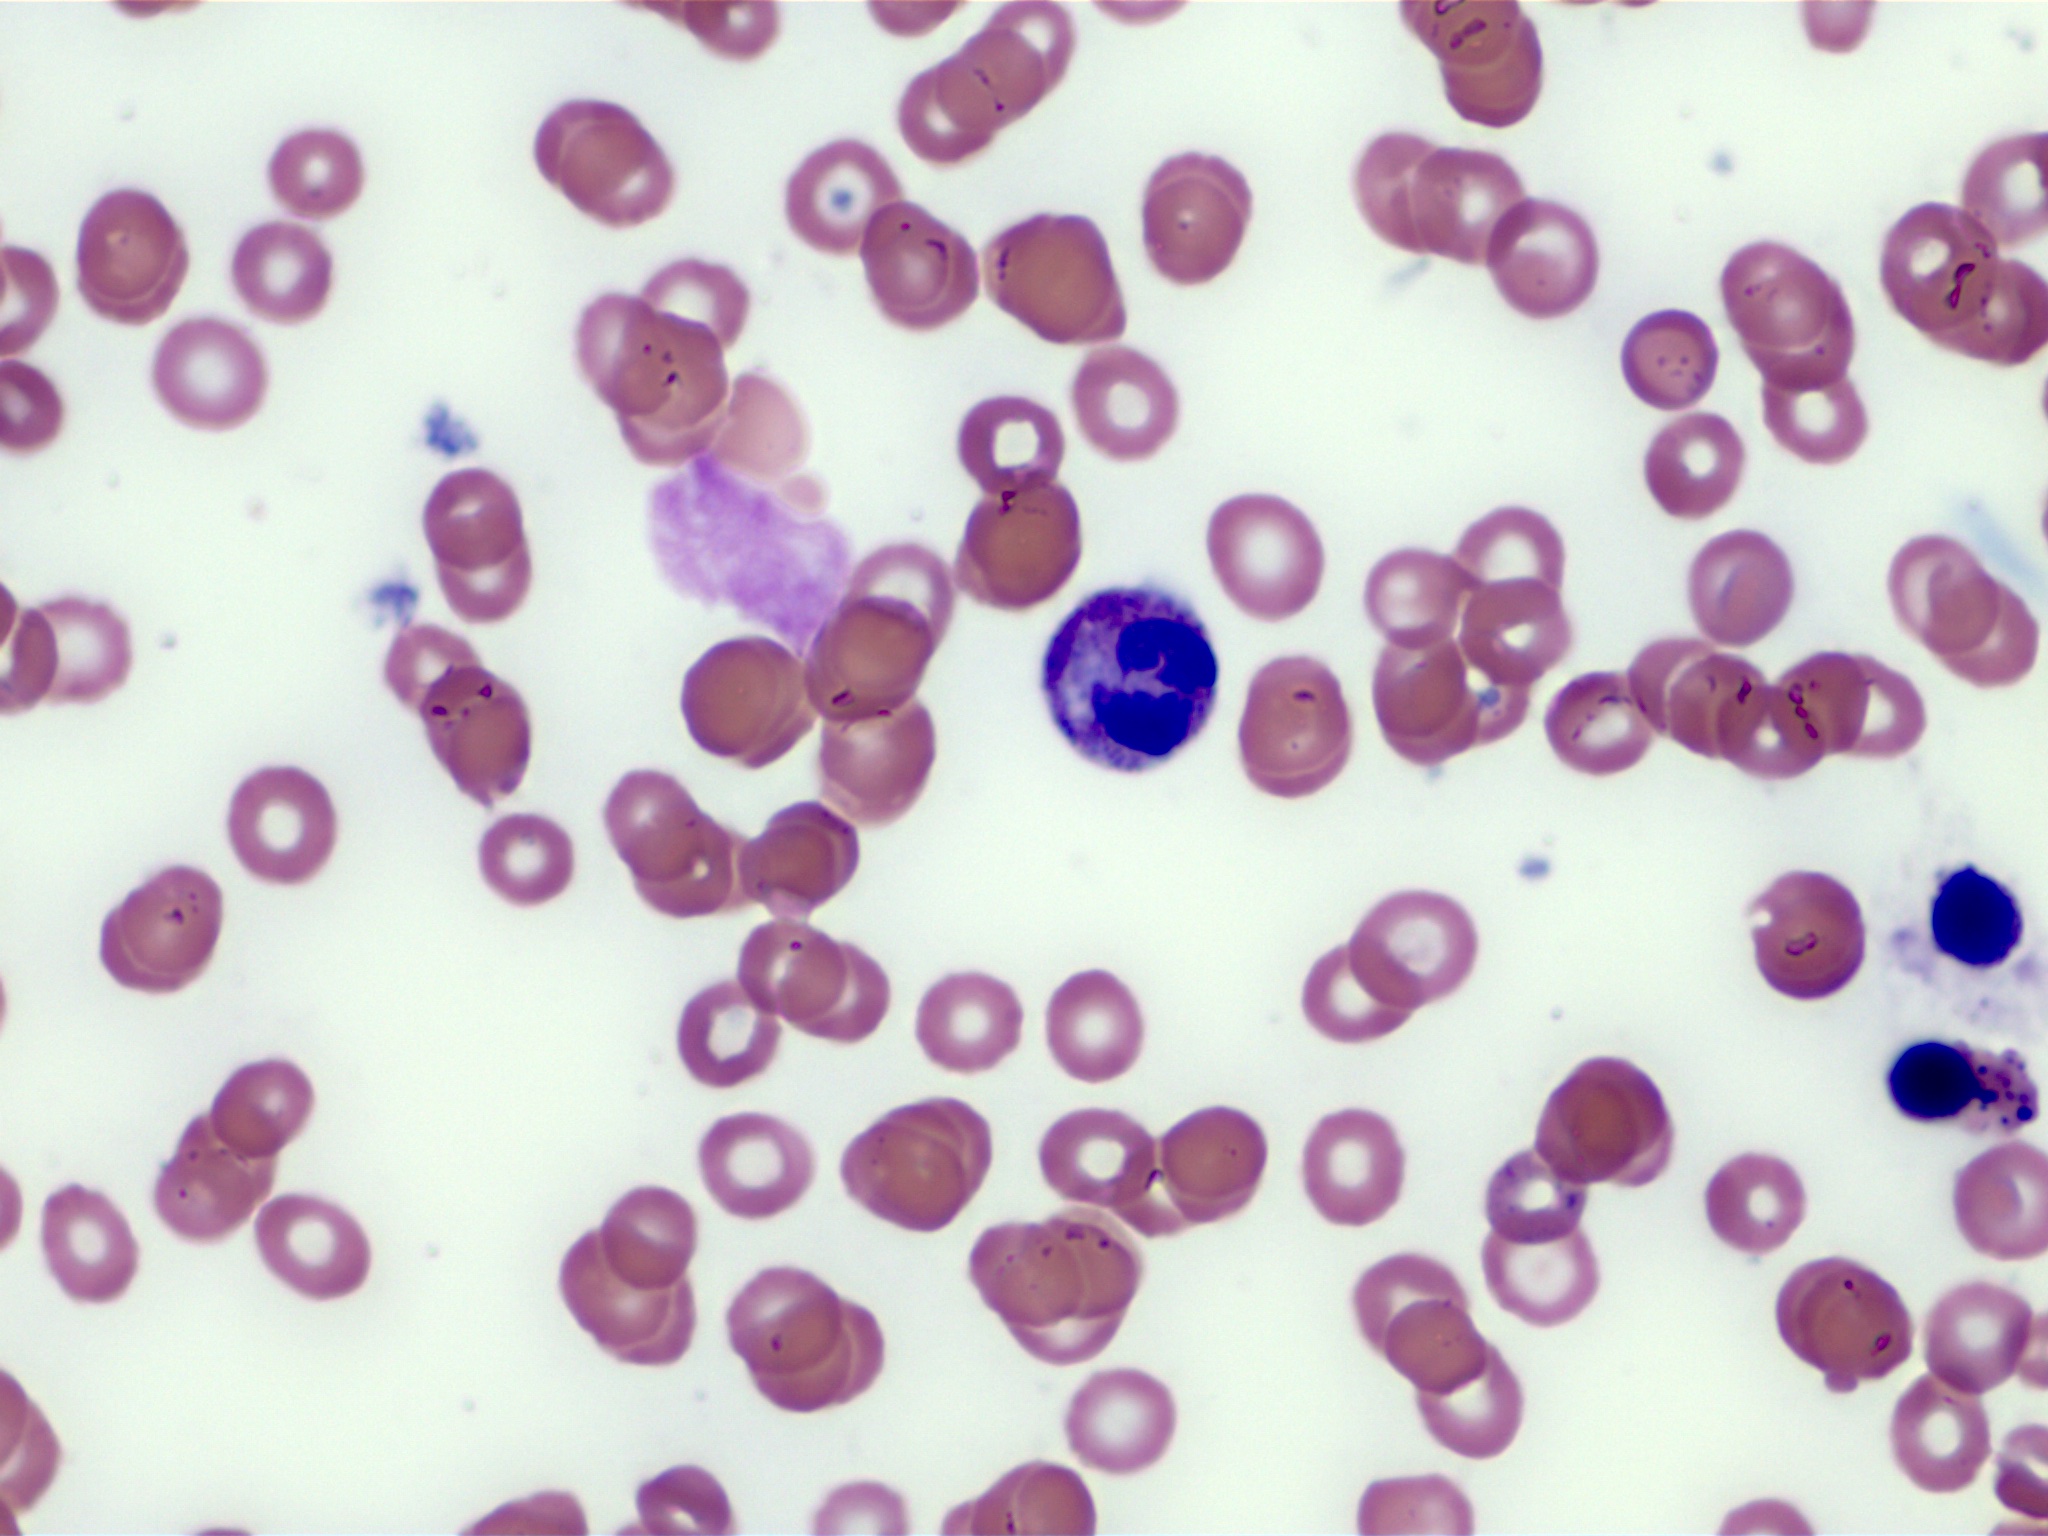
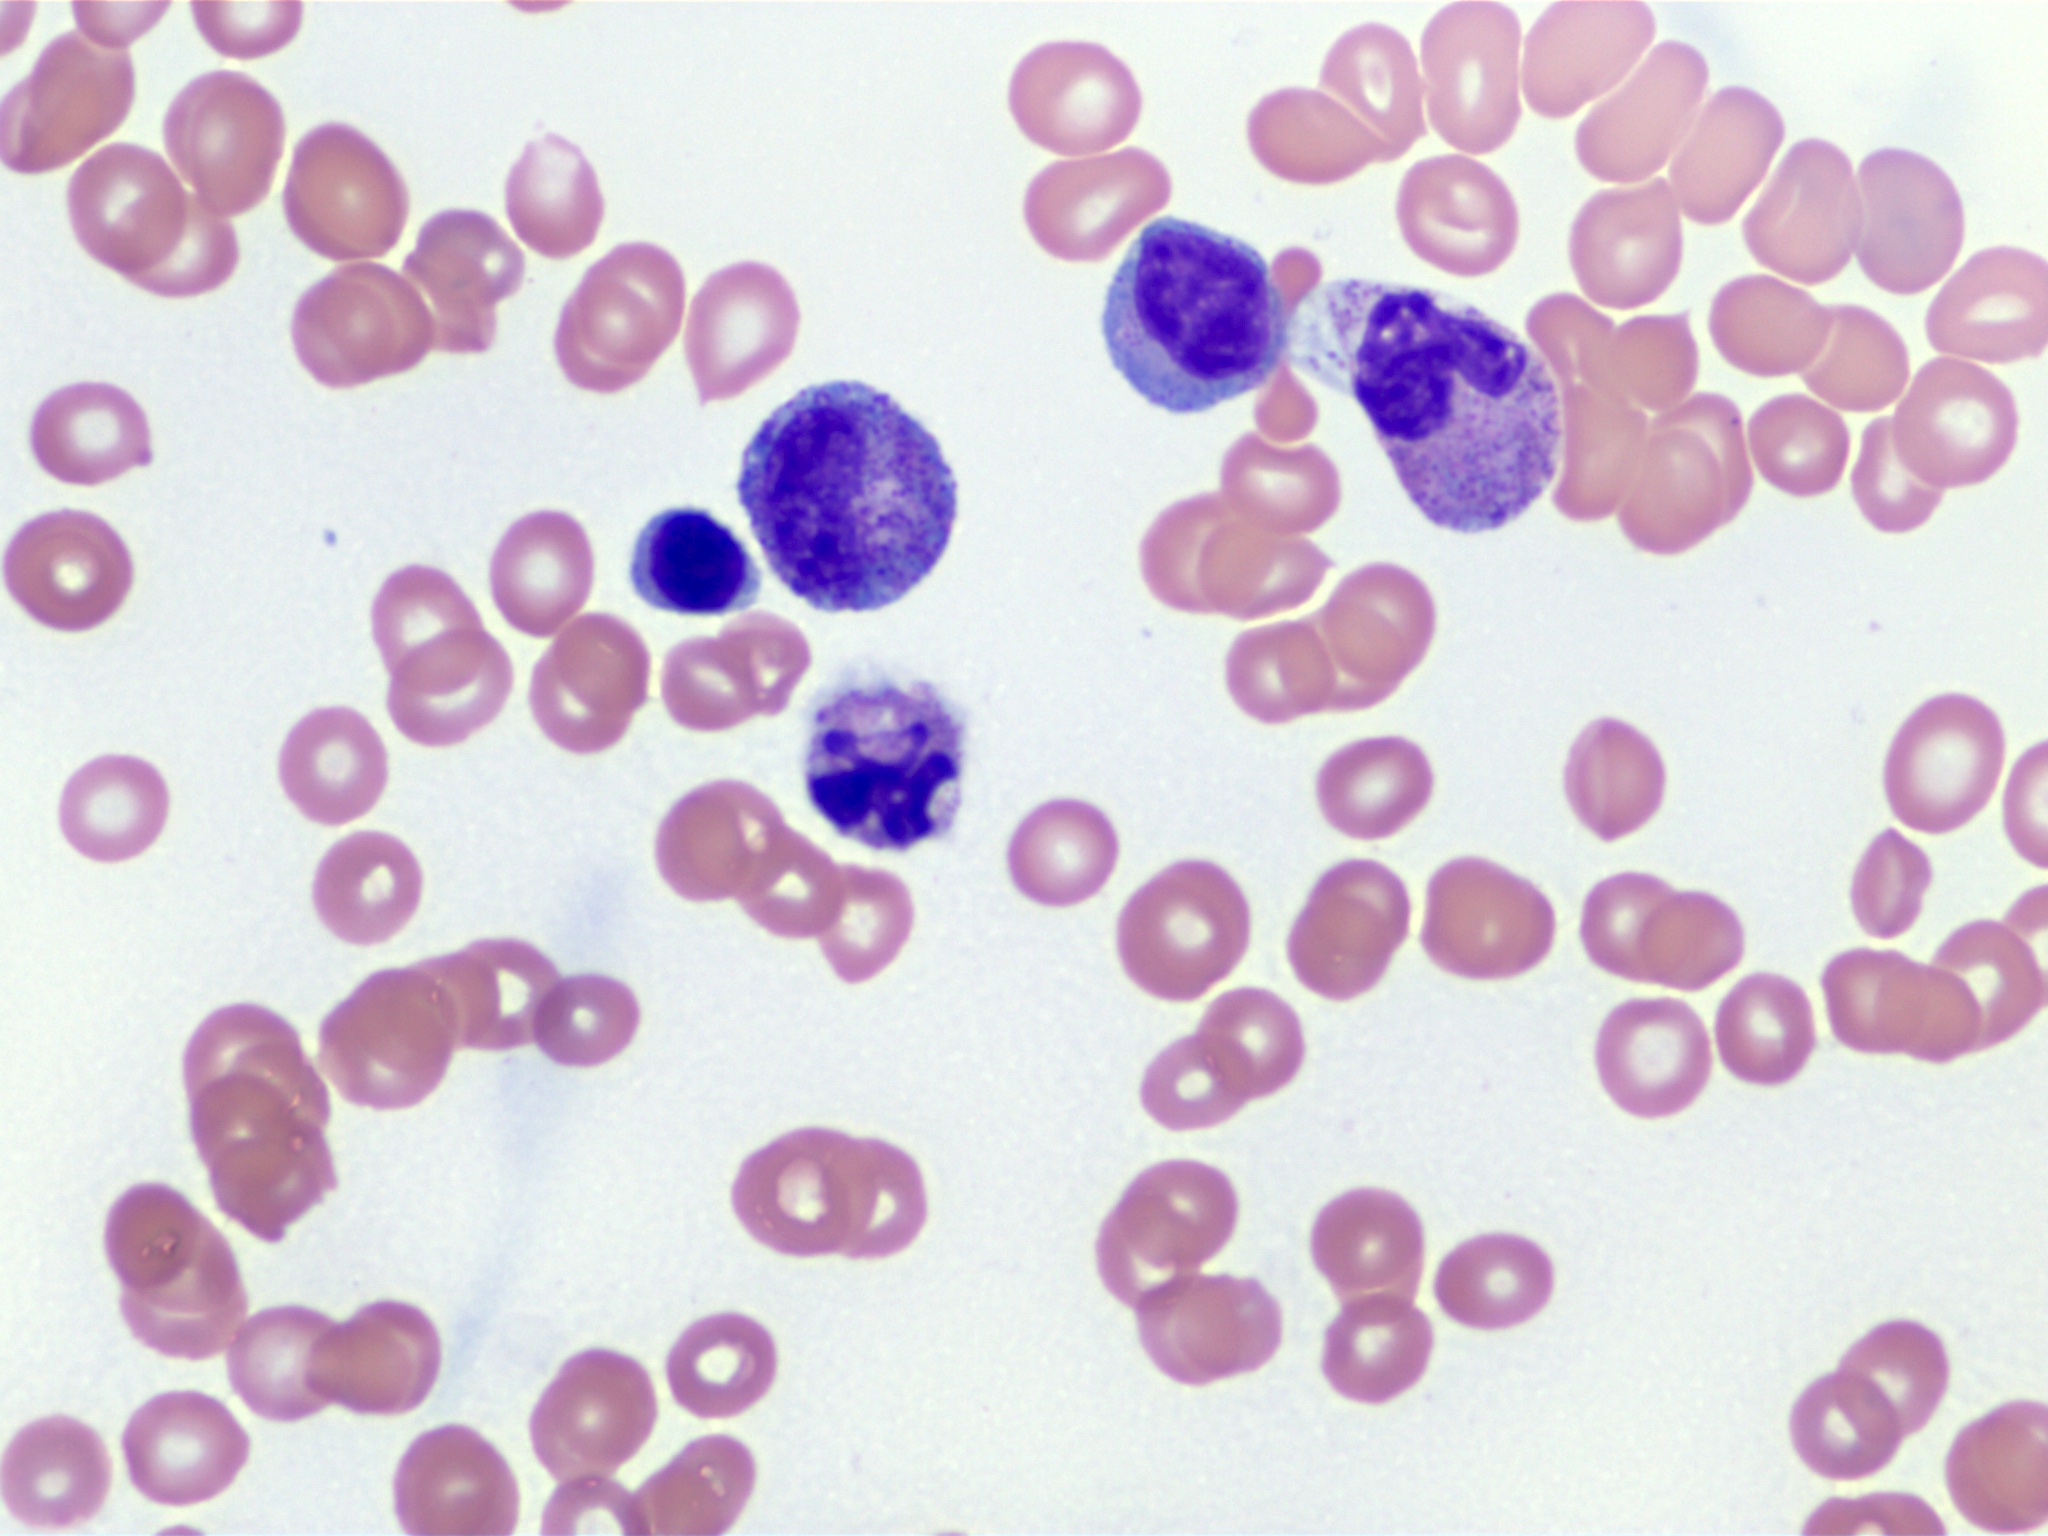

Table of Contents
Definition / general | Essential features | Terminology | ICD coding | Epidemiology | Sites | Pathophysiology | Etiology | Diagrams / tables | Clinical features | Diagnosis | Laboratory | Prognostic factors | Case reports | Treatment | Microscopic (histologic) description | Microscopic (histologic) images | Cytology description | Peripheral smear description | Positive stains | Molecular / cytogenetics description | Sample pathology report | Differential diagnosis | Additional references | Practice question #1 | Practice answer #1Cite this page: Pouraei A, Kaseb H. MDS / MPN, NOS (unclassifiable). PathologyOutlines.com website. https://www.pathologyoutlines.com/topic/myeloproliferativemdsmpnunclassified.html. Accessed October 4th, 2025.
Definition / general
- Myelodysplastic / myeloproliferative neoplasm, NOS (unclassifiable) (MDS / MPN, NOS) is characterized by the occurrence of clinical and pathologic features of both myelodysplastic and myeloproliferative neoplasms
- Diagnosis is based on exclusion of other myeloid neoplasm
- Not fulfilling criteria for other MDS / MPN entities, no history of growth factor or cytotoxic therapy or
- Absence of disease defining gene fusions, including BCR::ABL1 and rearrangements of PDGFRA, PDGFRB, FGFR1 or JAK2
Essential features
- De novo presentation
- MDS / MPN, NOS shows simultaneous presence of both myelodysplastic (cytopenias) and myeloproliferative (cytosis) features
- Diagnostic criteria for MDS / MPN, NOS include cytopenias with thresholds aligned with myelodysplastic syndromes (MDS): hemoglobin < 13 g/dL (men) or < 12 g/dL (women), absolute neutrophil count < 1.8 x 109/L or platelet count < 100 x 109/L
- Myeloproliferative features include thrombocytosis (platelet count ≥ 450 x 109/L) or leukocytosis (white blood cell count ≥ 13 x 109/L)
- Blast percentage in peripheral blood or bone marrow must be < 20%, as specified by both WHO and ICC classifications
- Diagnosis is based on exclusion of
- Other defined myeloid neoplasms
- Other MDS / MPN entities
- Cases of MDS or MPN that transform to MDS / MPN-like
- Absence of biallelic TP53 mutations
- No t(3;3), inv(3) or del5q (ICC)
- No specific cytogenetic / molecular abnormality defines MDS / MPN, NOS
- Intrinsic risk of developing into acute myeloid leukemia
Terminology
- MDS / MPN, NOS (unclassifiable)
ICD coding
Epidemiology
- Rare (~1% of myeloid neoplasms) (Cancer Epidemiol 2019;59:51)
- Affects elderly men ≥ 60 years (Front Oncol 2021;11:778741, Leukemia 2014;28:958)
- Median age at diagnosis is ~70 years
- Male predominance (> 60%)
Sites
- Bone marrow and peripheral blood are involved in majority of cases
- Other organs such as spleen, liver and other extramedullary tissues may be involved (Mod Pathol 2022;35:470)
- Spleen and liver are the most common sites of extramedullary involvement
- Hepatomegaly is less common but possible
Pathophysiology
- Clonal hematopoietic stem cell origin (Indian J Hematol Blood Transfus 2019;35:3)
- General nonspecific heterogeneous myeloid mutations drive the disease (WHO 5th edition)
- Common mutations include TET2, NRAS, RUNX1, CBL, SETBP1 and ASXL1 (Leukemia 2013;27:1852)
- Genetic mutations in genes related to RNA splicing (e.g., SRSF2), epigenetic regulation (e.g., ASXL1, DNMT3A), transcription factors (e.g., RUNX1) and signaling pathways (e.g., RAS) (Hematology Am Soc Hematol Educ Program 2011;2011:264, Annu Rev Pathol 2013;8:21)
- SETBP1 mutations have been identified in up to 10% of cases and could aid in supporting the diagnosis (Leukemia 2013;27:1852)
- TET2 mutation is seen in ~30% of cases
- Double gene mutations are possible; however, comutation of 3 and more genes is extremely rare (Leuk Res Rep 2020;14:100229)
- Palomo et al. has shown subgroups with distinct molecular signatures / subtypes in up to 60% of cases (Blood 2020;136:1851, Int J Hematol 2015;101:229)
- Chronic myelomonocytic leukemia (CMML)-like (17%), atypical chronic myeloid leukemia (aCML)-like / MDS / MPN with neutrophilia-like (33%), MDS / MPN-RS-T-like (11%), TP53 positive (13%) and others
- Molecular subgroups correlate with corresponding hematologic phenotypes and outcomes
- Increased SRSF2 / SETBP1 double mutant pattern noted in MDS / MPN with i(17q)
- MDS with del(5q) can be associated with JAK2 p.V617F (WHO 5th edition) (Mod Pathol 2022;35:470)
- It is recommended that cases with combined del(5q) and JAK2 p.V617F mutation be classified as MDS with isolated del(5q) rather than MDS / MPN, NOS
- Provisional entity: MDS / MPN with isolated isochromosome (17q), classified under MDS / MPN, NOS category according to the International Consensus Classification (ICC)
- Requires the presence of isochromosome (17q), either as an isolated abnormality or accompanied by one additional cytogenetic abnormality excluding monosomy 7 or (7q) deletion
- Deletion of 17p (leading to monoallelic TP53 loss without multihit or biallelic inactivation) and duplication of 17q
- Common mutations include SRSF2, SETBP1, ASXL1 and NRAS, with frequent co-occurrence of SRSF2 and SETBP1
- Partial overlap with aCML (e.g., SETBP1 / ASXL1) and to a lesser content, CMML (e.g., SRSF2 / NRAS) but distinguished by the defining cytogenetic change and the absence of multihit TP53 alterations (Virchows Arch 2023;482:69)
Etiology
- Unknown (WHO 5th edition)
- No specific genetic abnormality defines MDS / MPN, NOS; however, some genetic mutations could be disease drivers
- ASXL1 mutations: most common molecular abnormality found in 40 - 50% of MDS / MPN, NOS patients (Blood Res 2021;56:S51)
- TP53 mutations: MDS / MPN, NOS cases had a higher prevalence (~8%) of TP53 mutations compared to other MDS / MPN entities (Blood 2020;136:1851)
Diagrams / tables
Mutations and the pathways that were found in MDS / MPN, NOS (Int J Hematol 2015;101:229, Leukemia 2020;34:656, Mod Pathol 2022;35:470, Mod Pathol 2022;35:705)
| Signaling (most common) | Epigenetic regulators | Transcription factors | RNA splicing | ||
| Receptors | Signal transduction molecule | DNA methylation | Histone modifications | ||
| NRAS FLT3 CSF3R | CBL SETBP1 | DNMT3A TET2 IDH1/2 | ASXL1 EZH2 SUZ12 EED | RUNX1 CEBPA NPM1 WT1 TP53 | SRSF2 SF3B1 U2AF1 |
Clinical features
- No distinctive clinical manifestations
- Present with combined MDS-like and MPN-like features
- MDS-like symptoms: fatigue, dyspnea, infections and bleeding (Front Oncol 2021;11:778741)
- MPN-like symptoms: night sweats, weight loss and increased risk of thromboembolic complications (Front Oncol 2021;11:778741)
- Splenomegaly is observed in ~30% of cases (Leukemia 2014;28:958)
Diagnosis
Diagnostic criteria for myelodysplastic / myeloproliferative neoplasm (MDS / MPN), NOS (WHO 5th edition) (Leukemia 2022;36:1703)
Diagnostic criteria for myelodysplastic / myeloproliferative neoplasm (MDS / MPN), NOS (ICC) (Blood 2022;140:1200)
Proposed criteria for MDS / MPN with isolated isochromosome (17q) (Mod Pathol 2022;35:705)
- Peripheral blood: evidence of both cytopenias and proliferative features (see Essential features for specific thresholds)
- Bone marrow examination: dysplastic changes in hematopoietic cells and signs of proliferation
- Genetic testing on blood or bone marrow: mutations typical of both dysplastic and proliferative myeloid neoplasms
- Exclusion required for secondary myeloid neoplasms due to prior therapy, specific gene rearrangements (e.g., BCR::ABL1 or those involving PDGFRA, PDGFRB, JAK2 or FGFR1), cases with biallelic TP53 alterations and other defined MDS / MPN subtypes
- Certain MDS cases may progress to resemble MDS / MPN, NOS through development of proliferative characteristics
Diagnostic criteria for myelodysplastic / myeloproliferative neoplasm (MDS / MPN), NOS (ICC) (Blood 2022;140:1200)
- Myeloid disorder exhibiting combined proliferative and dysplastic traits that does not align with criteria for any other specific myeloid neoplasms per WHO
- Cytopenia (meeting MDS thresholds as defined in Essential features)
- Blast cells accounting for < 20% in both blood and bone marrow
- Elevated platelets (≥ 450 x 109/L) or white blood cells (≥ 13 x 109/L)
- Confirmation of clonality through cytogenetic changes or somatic mutations
- If clonality is not demonstrable, persistent findings over time with ruled out alternative causes (e.g., prior cytotoxic exposure or other etiologies mimicking the overlap features)
- Absence of BCR::ABL1 fusion or genetic changes linked to myeloid / lymphoid neoplasms with eosinophilia and tyrosine kinase fusions; no t(3;3)(q21.3;q26.2), inv(3)(q21.3;q26.2) or isolated del(5q)
- Subtype inclusion: MDS / MPN with isolated i(17q) as a specific variant
Proposed criteria for MDS / MPN with isolated isochromosome (17q) (Mod Pathol 2022;35:705)
- Myeloid disorder presenting with both proliferative and dysplastic characteristics from onset, not qualifying for any other MDS / MPN, MDS or MPN subtype per WHO
- Blast proportion under 20% in peripheral blood and bone marrow
- Dysplastic elements akin to MDS, paired with proliferative signs such as platelets ≥ 450 x 109/L with megakaryocytic hyperplasia in bone marrow or white blood cells ≥ 13 x 109/L
- Cytogenetics showing isolated i(17q) or i(17q) plus one other abnormality [not including del(7q) or -7]
- No fusions involving BCR::ABL1, PDGFRA, PDGFRB, FGFR1 or PCM1::JAK2
- Lack of typical MPN driver mutations (e.g., in JAK2, CALR or MPL)
- No recent exposure to cytotoxic agents or growth factor therapy that could account for the myelodysplastic / myeloproliferative features
Laboratory
- CBC with differential count and morphologic review
- Variable; at least 1 cytopenia in blood, at least 1 cytosis in blood (Virchows Arch 2023;482:69, PDQ Cancer Information Summaries: Myelodysplastic / Myeloproliferative Neoplasms Treatment (PDQ®) - Health Professional Version [Accessed 22 August 2025])
- Cytosis seems to be more common than cytopenia, with leukocytosis as the most common finding
- Among cytopenia; anemia is most common
- Percentage of blasts in peripheral blood and bone marrow must be < 20%
- Circulating blasts are typically absent but bone marrow blasts may be ≤ 5% (PDQ Cancer Information Summaries: Myelodysplastic / Myeloproliferative Neoplasms Treatment (PDQ®) - Health Professional Version [Accessed 22 August 2025])
- Increased lactate dehydrogenase (LDH)
Prognostic factors
- Poor prognosis (Front Oncol 2021;11:778741, Mod Pathol 2022;35:705)
- Overall survival (OS): 12 - 32 months (Mod Pathol 2022;35:705)
- i(17q) is an independent predictor of worse outcome in MDS / MPN, NOS (Mod Pathol 2022;35:705)
- Factors associated with worse outcomes (Clin Lymphoma Myeloma Leuk 2019;19:1, Int J Mol Sci 2024;25:10214, PDQ Cancer Information Summaries: Myelodysplastic / Myeloproliferative Neoplasms Treatment (PDQ®) - Health Professional Version [Accessed 22 August 2025], Blood Adv 2023;7:7554)
- Many myeloid genes are associated with unfavorable outcome, e.g., RUNX1 and TP53 mutations (Leuk Res Rep 2020;14:100229)
- Age ≥ 65
- Leukocytosis
- Anemia
- Low platelet count
- Circulating blast ≥ 5%
Case reports
- 17 year old boy with acute myeloid leukemia (AML) arising from MDS / MPN, NOS, developed 2 years after starting immunosuppressive therapy for juvenile idiopathic arthritis (JIA) (J Med Invest 2024;71:335)
- 42 year old man with MDS / MPN, NOS with a t(x;17)(q28;q21) chromosomal rearrangement resulting in the KANSL1::MTCP1 fusion gene (Cytogenet Genome Res 2021;161:564)
- 46 year old man with adrenal infarction associated with a latent MDS / MPN, NOS, featuring a JAK2 V617F mutation (Clin Case Rep 2024;12:e8729)
- 57 year old man with MDS / MPN, NOS with comutations of JAK2, TP53 and SF3B1 treated with ruxolitinib (Leuk Res Rep 2020;14:100229)
- 61 year old man with prominent erythroid dysplasia and t(8;9) progressing to acute erythroid leukemia (Hum Pathol 2005;36:1148)
- 81 year old man with recurrent bilateral adrenal infarction with MDS / MPN, NOS (BMC Endocr Disord 2023;23:128)
Treatment
- Treatment for patients with MDS / MPN, NOS is based on therapies used for MDS or MPN
- Leukocytosis can be managed with cytoreductive therapies (Leuk Res Rep 2020;14:100229)
- Hydroxyurea
- Ruxolitinib (JAK inhibitor)
- Supportive care and symptom management
- Erythropoietin stimulating agents (ESA) are commonly used for anemia, particularly in patients with ring sideroblasts (Blood Cancer J 2022;12:26)
- Lenalidomide and immunosuppressive therapy may address cytopenias in lower risk cases (J Clin Med 2021;10:2107)
- Hypomethylating agents (HMAs)
- Azacitidine or decitabine are standard for higher risk MDS / MPN though data specific to MDS / MPN, NOS are limited (J Clin Med 2021;10:2107, Curr Oncol 2024;31:1971)
- Emerging combinations (e.g., venetoclax + azacitidine) show promise in refractory cases (Cell Rep Med 2023;4:100940, J Clin Med 2021;10:2107)
- Targeted therapies
- Luspatercept for ring sideroblast associated anemia and TGFβ modulators (e.g., sotatercept) are under investigation in trials (Blood Cancer J 2022;12:26, J Clin Med 2021;10:2107)
- Splicing inhibitors (e.g., imetelstat) and BCL2 inhibitors (venetoclax) are being explored in clinical trials (Blood Cancer J 2022;12:26, J Clin Med 2021;10:2107)
- For high risk cases, allogeneic stem cell transplantation remains the only curative option (Curr Oncol 2024;31:1971)
Microscopic (histologic) description
- Bone marrow (Front Oncol 2021;11:778741)
- Hypercellular or hypocellular
- Hypercellular with myeloid lineage predominance
- Dysplasia is seen in at least one hematopoietic lineage
- Percentage of blasts in peripheral blood and bone marrow must be < 20%
- Typically few blasts are seen
- Include promonocytes as blast equivalents
- Bone marrow fibrosis is seen in up to 30%
- Increased megakaryocytes with variable clustering
- Often myelodysplasia-like with small size and nuclear hypolobation
- MDS / MPN with iso(17q) typically shows the myelodysplasia-like megakaryocytes
- Transformations of either MDS or MPN should not be included within MDS / MPN categories
- Hypercellular or hypocellular
Microscopic (histologic) images
Cytology description
Peripheral smear description
- Leukocytosis, thrombocytosis (Front Oncol 2021;11:778741)
- Peripheral blood smears in MDS / MPN, NOS often show dysplastic neutrophils characterized by (Haematologica 2025;110:300)
- Hypogranularity (reduced or absent cytoplasmic granules)
- Nuclear hypolobation (e.g., pseudo-Pelger-Huët anomaly with bilobed or unilobed nuclei instead of the normal multilobated structure)
- Abnormal nuclear chromatin clumping or irregular nuclear contours
- Circulating blasts are typically absent or ≤ 5% in bone marrow, with peripheral blasts rarely observed (Front Oncol 2021;11:778741)
Positive stains
- CD34: highlights blasts in bone marrow or peripheral blood but also stains hematopoietic progenitor cells, endothelial cells and some stromal cells
- Reticulin: assesses fibrosis
- Prussian blue stain: ring sideroblasts < 10%
- CD117
- CD61 / CD42b: identifies dysplastic megakaryocytes
- p53 overexpression, detected by immunohistochemistry, often correlates with TP53 mutations in MDS / MPN, NOS (seen in ~8% of cases)
- However, not all cases with TP53 mutations show p53 overexpression and overexpression can occur without TP53 mutations due to other mechanisms (e.g., MDM2 dysregulation)
- Thus, p53 staining is not a definitive marker for TP53 mutations but supports their presence when strongly positive
- Biallelic TP53 mutations are excluded in MDS / MPN, NOS diagnosis
- References: Mod Pathol 2022;35:470, Front Oncol 2024;14:1415101
Molecular / cytogenetics description
- No specific genetic marker (WHO 5th edition); the presence of myeloid genetic mutations will support clonality
- Mutations of ASXL1, TET2, JAK2, SRSF2, EZH2 and SETBP1 common
- Most mutations have been associated with an adverse outcome
- ≥ 1 mutation adverse prognosis
- TP53 mutations linked to adverse outcome (Blood Cancer J 2016;6:e385, Blood Res 2021;56:S51)
- Common abnormalities include trisomy 8, monosomy 7 / 7q deletion, 20q deletion and a monosomal or a complex karyotype (Cancers (Basel) 2021;13:2120)
- Negative for disease defining gene fusions, such as BCR::ABL1 or rearrangement of PDGFRA, PDGFRB, JAK2 or FGFR1, biallelic TP53 mutations and other MDS / MPN entities, such as SF3B1 mutation any AML defining genotype, t(3;3), inv(3) (Leukemia 2014;28:958, Blood 2016;127:2391)
- Isolated isochromosome 17q required for MDS / MPN with iso(17q) (ICC) (Oncotarget 2016;7:14251, Am J Hematol 2025;100:5)
Sample pathology report
- Bone marrow aspirate and posterior iliac crest core biopsy:
- MDS / MPN neoplasm, favor MDS / MPN, NOS (see comment)
- Comment: The marrow biopsy shows morphologic features of MDS and MPN. Bone marrow showed multilineage dysplasia and 4.2% blasts. No ring sideroblasts were observed.
Differential diagnosis
- Chronic myelomonocytic leukemia (Virchows Arch 2023;482:69):
- Persistent absolute monocytosis (≥ 0.5 x 109/L) with monocytes accounting for ≥ 10% of the leukocytes
- Coexistence of SRSF2 and TET2 mutations in particular is highly suggestive of CMML
- MDS / MPN with neutrophilia / aCML (Virchows Arch 2023;482:69):
- Leukocytosis (white blood cell count ≥ 13 x 109/L) due to neutrophilia, with ≥ 10% immature myeloid cells (e.g., promyelocytes, myelocytes, metamyelocytes)
- Peripheral blood shows dysplastic neutrophils (e.g., hypogranularity, pseudo-Pelger-Huët anomaly)
- Bone marrow findings include hypercellularity with myeloid predominance, dysplastic neutrophils and < 20% blasts
- Common mutations include SETBP1, ASXL1, NRAS, KRAS, SRSF2 and TET2, with SETBP1 and ASXL1 comutations frequent
- BCR::ABL1 fusion is absent
- MDS / MPN with SF3B1 mutation and thrombocytosis:
- Anemia associated with erythroid lineage dysplasia, with or without multilineage dysplasia; ≥ 15% ring sideroblasts
- Persistent thrombocytosis, with platelet count ≥ 450,000/μL
- < 5% blasts in bone marrow
- SF3B1 mutation (variant allele frequency ≥ 10%) and concurrent JAK2 p.V617F or in the absence of JAK2 p.V617F, mutation in another myeloproliferative gene such as MPL or CALR
- MDS:
- Myelodysplastic syndrome with isolated del(5q) diagnostic criteria (WHO 5th edition):
- There is a del(5q) cytogenetic abnormality [isolated or with one additional abnormality, excluding -7/del(7q)]
- Anemia (hemoglobin < 13 g/dL in men or < 12 g/dL in women)
- < 5% blasts in bone marrow and < 1% in peripheral blood
- Bone marrow shows megakaryocytic dysplasia (e.g., hypolobated megakaryocytes) and often ≥ 15% ring sideroblasts
- Myelodysplastic syndrome with isolated del(5q) diagnostic criteria (WHO 5th edition):
Additional references
Practice question #1
A 65 year old man presents with fatigue and thrombocytosis. Bone marrow biopsy reveals atypical megakaryocytes and dysplastic erythroid elements. No ring sideroblasts are identified. Cytogenetic analysis shows no BCR::ABL1 fusion, PDGFRA / PDGFRB rearrangement or del(5q). Flow cytometry revealed rare blasts (1%) with no aberrant immunophenotypic expression. Based on WHO criteria for MDS / MPN, NOS, which of the following findings would confirm the diagnosis?
- Increased lactate dehydrogenase (LDH)
- Peripheral blood monocyte count > 1 x 109/L
- Presence of SETBP1 mutations
- Ring sideroblasts with thrombocytosis
Practice answer #1
C. Presence of SETBP1 mutations. MDS / MPN, NOS is characterized by overlapping features of myelodysplastic syndromes and myeloproliferative neoplasms but lacks specific criteria for other subtypes. SETBP1 mutation is seen in 10% of MDS / MPN, NOS patients and is generally the most specific marker seen in MDS / MPN, NOS.
Answer B is incorrect because it is a diagnostic criterion for chronic myelomonocytic leukemia (CMML), a distinct MDS / MPN subtype. The patient's presentation lacks monocytosis, making this irrelevant.
Answer D is incorrect because ring sideroblasts and thrombocytosis define MDS / MPN-RS-T, a separate entity. This patient's thrombocytosis and dysplasia without ring sideroblasts align with MDS / MPN, NOS, not MDS / MPN-RS-T.
Answer A is incorrect because elevated LDH reflects tumor burden but does not confirm the diagnosis.
Comment Here
Reference: MDS / MPN, NOS (unclassifiable)
Comment Here
Reference: MDS / MPN, NOS (unclassifiable)